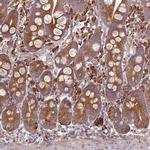
FAT4 Antibody in Immunohistochemistry (IHC)

Search
Invitrogen
FAT4 Polyclonal Antibody
{{$productOrderCtrl.translations['antibody.pdp.commerceCard.promotion.promotions']}}
{{$productOrderCtrl.translations['antibody.pdp.commerceCard.promotion.viewpromo']}}
{{$productOrderCtrl.translations['antibody.pdp.commerceCard.promotion.promocode']}}: {{promo.promoCode}} {{promo.promoTitle}} {{promo.promoDescription}}. {{$productOrderCtrl.translations['antibody.pdp.commerceCard.promotion.learnmore']}}
产品信息
PA5-62694
种属反应
宿主/亚型
分类
类型
抗原
偶联物
形式
浓度
规格
纯化类型
保存液
内含物
保存条件
运输条件
RRID
产品详细信息
Immunogen sequence: FDDPDNIPPY GDDMTVRKQP EGNPKPDIIE RENPYLIYDE TDIPHNSETI PSAPLASPEQ EIEHYDIDNA SSIAPSDADI IQHYKQFRSH T
Highest antigen sequence identity to the following orthologs: Mouse - 97%, Rat - 97%.
靶标信息
FAT1, FAT2, FAT3 and FAT4 are human homologs of Drosophila Fat, which is involved in tumor suppression and planar cell polarity (PCP). FAT4 undergo the first proteolytic cleavage by Furin and are predicted to undergo the second cleavage by secretase to release intracellular domain (ICD). FAT4 directly interacts with MPDZ/MUPP1 to recruit membrane associated guanylate kinase MPP5/PALS1. FAT4 is involved in the maintenance of PCP and inhibition of cell proliferation.
仅用于科研。不用于诊断过程。未经明确授权不得转售。
篇参考文献 (0)
生物信息学
蛋白别名: Cadherin family member 14; cadherin-related family member 11; FAT tumor suppressor homolog 4; Fat-like cadherin protein FAT-J; hFat4; Protocadherin Fat 4; putative protein product of Nbla00548; unnamed protein product
基因别名: CDHF14; CDHR11; FAT-J; FAT4; FATJ; HKLLS2; NBLA00548; VMLDS2
UniProt ID: (Human) Q6V0I7
Entrez Gene ID: (Human) 79633